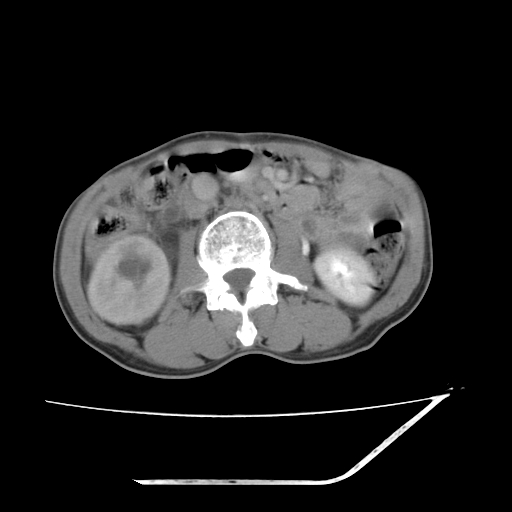
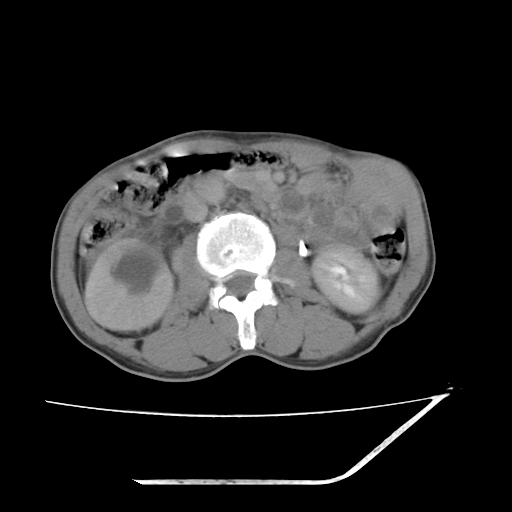

[本贴已被 翁志蓬 于 2008-10-19 2:25:30 修改过][/
作者: 余辉
时间: 2008-10-18 23:46
考虑右肾盂癌,肾动脉受侵,右肾功能减退,右肾盂输尿管积水,管壁增厚,考虑种植转移,应该把下面扫完的
作者: 杀毒软件
时间: 2008-10-18 23:50
挺典型
作者: 深泽交通
时间: 2008-10-19 00:11
标题: 回复:典型病例共享。
以下是引用余辉在2008-10-18 15:46:00的发言:[br]考虑右肾盂癌,肾动脉受侵,右肾功能减退,右肾盂输尿管积水,管壁增厚,考虑种植转移,应该把下面扫完的
作者: 吴承学
时间: 2008-10-19 00:17
标题: 回复:典型病例共享。
以下是引用杀毒软件在2008-10-18 15:50:00的发言:[br]挺典型
作者: sdzyy
时间: 2008-10-19 00:53
支持
作者: zjzjr
时间: 2008-10-19 01:14
支持右侧肾盂癌伴肾静脉瘤栓形成可能性大,右肾结石.肝右叶后段低密度影,不除外转移.
作者: 吴承学
时间: 2008-10-19 02:00
标题: 回复:典型病例共享。
以下是引用zjzjr在2008-10-18 17:14:00的发言:[br]支持右侧肾盂癌伴肾静脉瘤栓形成可能性大,右肾结石.肝右叶后段低密度影,不除外转移.
作者: 52yingxiang
时间: 2008-10-19 03:34
标题: 回复:典型病例共享。
以下是引用余辉在2008-10-18 15:46:00的发言:[br]考虑右肾盂癌,肾动脉受侵,右肾功能减退,右肾盂输尿管积水,管壁增厚,考虑种植转移,应该把下面扫完的
作者: shiqingfa
时间: 2008-10-19 03:40
考虑右肾盂癌,肾动脉受侵,右肾功能减退,右肾盂输尿管积水,管壁增厚,考虑种植转移 支持
作者: jtq4837
时间: 2008-10-19 03:44
标题: 回复:典型病例共享。
海林的吴承学吗,
作者: gjj6818
时间: 2008-10-19 03:45
标题: 回复:典型病例共享。
以下是引用余辉在2008-10-18 15:46:00的发言:[br]考虑右肾盂癌,肾动脉受侵,右肾功能减退,右肾盂输尿管积水,管壁增厚,考虑种植转移,应该把下面扫完的
作者: jtq4837
时间: 2008-10-19 03:47
标题: 回复:典型病例共享。
海林的吴承学吗
作者: ydx_74
时间: 2008-10-19 04:19
支持有肾盂癌
作者: 流浪星
时间: 2008-10-19 04:34
考虑右肾盂癌,肾动脉受侵,右肾功能减退,右肾盂输尿管积水,管壁增厚,考虑种植转移 支持
作者: LIAOQIANG
时间: 2008-10-19 04:39
考虑右侧肾盂癌。右侧输尿管扩张未扫描完。
作者: 358450m
时间: 2008-10-19 04:44
标题: 回复:典型病例共享。
以下是引用shiqingfa在2008-10-18 19:40:00的发言:[br]考虑右肾盂癌,肾动脉受侵,右肾功能减退,右肾盂输尿管积水,管壁增厚,考虑种植转移 支持
作者: panyishengct
时间: 2008-10-19 04:52
考虑右肾盂癌,右肾功能减退,右肾盂输尿管积水,管壁增厚,考虑种植转移 支持
作者: zhengfaming
时间: 2008-10-19 05:08
右肾囊实性占位,支持肾癌,窗宽窗位不是很理想
作者: 医中人
时间: 2008-10-19 06:37
右肾盂旁ca并肾静脉瘤栓形成/肾功能降低。
右肾结石。
作者: liuhongjun01
时间: 2008-10-19 07:48
右肾盂癌,肾动脉受侵,右肾盂输尿管积水,管壁增厚,考虑种植转移
作者: SOS.LA
时间: 2008-10-19 14:13
右肾盂移行细胞癌并右输尿管中段转移.肾积水.
作者: QINGJING
时间: 2008-10-19 15:42
谢谢
作者: 随光逐影
时间: 2008-10-19 16:17
支持 右侧肾盂癌伴肾静脉瘤栓形成可能性大,右肾结石;肝右叶后段低密度影,不除外转移。
作者: zsl6918
时间: 2008-10-19 16:23
敬请楼主谈谈如何典型,让大家一起学习学习.
作者: 宇宙CT
时间: 2008-10-19 17:12
考虑右肾盂癌,肾动脉受侵,右肾功能减退,右肾盂输尿管积水,管壁增厚,考虑种植转移 支持
作者: liuyue
时间: 2008-10-19 19:55
1.右侧肾盂癌伴肾盂积水。
2.肾脏功能减退,原因有:(1)肾动脉受侵。(2)肾静脉受侵(3)肾积水,等。本例,肾动脉显影较好,但受压明显;肾静脉无明显显示,受压或静脉癌栓,下腔静脉腔内未见明显充盈缺损。
3.右侧上段输尿管扩张,原因:(1)积水所致;(2)种植。
作者: 黑白光影
时间: 2008-10-19 22:26
标题: 回复:ct16216:典型病例共享。
以下是引用余辉在2008-10-18 15:46:00的发言:[br]考虑右肾盂癌,肾动脉受侵,右肾功能减退,右肾盂输尿管积水,管壁增厚,考虑种植转移,应该把下面扫完的
作者: jinguoji
时间: 2008-10-20 01:36
标题: 回复:ct16216:典型病例共享。
以下是引用zjzjr在2008-10-18 17:14:00的发言:[br]支持右侧肾盂癌伴肾静脉瘤栓形成可能性大,右肾结石.肝右叶后段低密度影,不除外转移.
作者: dr.yang
时间: 2012-4-27 00:59
支持右侧肾盂癌伴肾静脉瘤栓形成可能性大,右肾结石.肝右叶后段低密度影,不除外转移.
| 欢迎光临 医影在线 (http://bbs.radida.com/bbs/) |
Powered by Discuz! X3.2 |